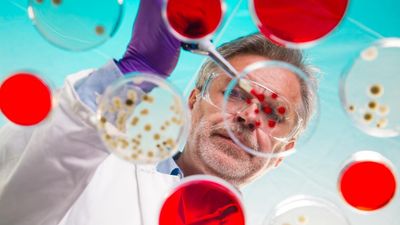
2024/05/21_07_2023_Candida-vaginale-idrogel-a-base-di-probiotici-potrebbe-trattare-il-disturbo-e-supportare-il-microbiota-1024x683-1.jpg

Trajtimi Ayurveda për Kandida – tetë këshilla shumë të rëndësishme!
Dy strategjitë më të rëndësishme në Ayurveda për trajtimin e kandidës janë stimulimi i zjarrit tretës dhe forcimi i sistemit imunitar me ndihmën e disa ushqimeve dhe bimëve mjekësore
Për ta arritur këtë rekomandohet një terapi të paktën dymujore, e cila përfshin këshillat e mëposhtme!
Candida albicans është një lloj myku që jeton në simbiozë me trupin e njeriut dhe gjendet në gojë, në lëkurë, në zorrë dhe në vagjinë. Ndërsa trupi është në një ekuilibër natyral, kandida është e pranishme në trupin tonë në sasi më të vogla, sepse është nën kontrollin e probiotikëve - të ashtuquajturat baktere të mira që ruajnë florën e zorrëve të shëndetshme dhe mbrojnë imunitetin.
Nëse ka një çekuilibër, kandida riprodhohet në mënyrë të panatyrshme dhe mbizotëron popullsinë e zorrëve të baktereve të mira. Nëse shumohet në mënyrë të pakontrolluar, kjo kërpudhë e padëshiruar mund të hyjë në qarkullimin e gjakut dhe të shkaktojë simptoma të tilla si:
▪ lodhje dhe pagjumësi
▪ oreks i dobët
▪ imuniteti i reduktuar
▪ marramendje dhe zhurmë në vesh
▪ kollë e vazhdueshme
▪ vështirësi në përqendrim dhe përqendrim
▪ dhimbje të ndryshme trupore dhe probleme me tretjen
Një çrregullim i tillë në organizëm ndikohet nga shumë faktorë si vitaliteti i dobët, çekuilibri i sistemit tretës, dobësimi i fuqisë tretëse, grumbullimi i toksinave në organizëm, higjiena dhe dieta jo e duhur, mënyra e jetesës jo e shëndetshme dhe përdorimi i shpeshtë i antibiotikëve, transmeton Telegrafi.
Sipas Ayurveda, çekuilibri fillon në sistemin tretës dhe tretja është ajo që duhet të balancohet së pari. Për shkak të një diete të varfër të pasur me ëmbëlsira dhe karbohidrate të rënda, fuqia tretëse zvogëlohet dhe kështu çon në akumulimin e toksinave në sistemin tretës. Helmet e tretjes nxisin përkeqësimin dhe funksionin e lubrifikimit të trupit.
Megjithëse infeksioni me kandida është kryesisht një çrregullim. Për shkak të riprodhimit të tyre, ka një shqetësim në aktivitetin e enzimave për të cilat është përgjegjëse për tretjen.
Këto çrregullime dobësojnë sistemin imunitar dhe imuniteti i dobët mundëson riprodhimin e shpejtë të kandidës dhe infeksione të mëtejshme.
Trajtimi i kandidës me ndihmën e Ayurveda-s
Dy strategjitë më të rëndësishme në Ayurveda për trajtimin e kandidës janë stimulimi i tretjes dhe forcimi i sistemit imunitar me ndihmën e disa ushqimeve dhe bimëve mjekësore.
Për ta arritur këtë, rekomandohet një terapi prej të paktën 2 muajsh, e cila përfshin këshillat e mëposhtme:
1. Filloni ditën tuaj me çaj limoni, xhenxhefili dhe pak qimnon. Pini filxhanin e përgatitur me çaj të nxehtë 30 minuta para kafjallit për të stimuluar largimin e toksinave nga trupi.
2. Pini dy herë në ditë, para ngrënies, gjysmë gote me lëng xhenxhefili të saposhtrydhur dhe hani dy thelpinj hudhër. Hudhra dhe xhenxhefili janë aleatë të shkëlqyer në luftën kundër kandidës.
3. Përdorni erëza ngrohëse në ushqime si piper i zi, arrëmyshk, kardamom, piper i kuq dhe piper djegës, xhenxhefil, shafran i Indisë, kanellë dhe karafil pasi janë të dobishëm në stimulimin e tretjes.
4. Shmangni ëmbëlsirat, ushqimet e yndyrshme, të skuqura, të rënda, të ftohta dhe të papërpunuara – kjo përfshin sallatat e frutave të papërpunuara pasi sheqeri i frutave ushqen kandidën. Mollët e gatuara me erëza janë zgjidhja më e mirë e frutave gjatë kësaj diete.
5. Hani ushqime lehtësisht të tretshme si supa, perime të ziera, qull tërshëre, të cilat janë shumë të dobishme kur gatuhen me erëza ngrohëse dhe barishte si sherbelë, temjan, rigon dhe livandë.
6. Gargara e vajit në gojë mund të jetë një trajtim shumë i dobishëm për kandidën. Në mëngjes, para se të lani dhëmbët, merrni 1 lugë gjelle vaj kokosi dhe lëreni në gojë për 10-15 minuta. Përsëriteni procedurën në mbrëmje para se të shkoni në shtrat. Përdorimi i vajit të kokosit dy herë në ditë për një muaj ndihmon në largimin e toksinave të tepërta nga trupi përmes mukozës së gojës dhe qetëson infeksionin me kandidën në atë zonë. Vaji i kokosit është gjithashtu një ilaç efektiv kundër kandidës kur përdoret në dietë.
7. Janë disa ushqime me veti të veçanta kuruese që mund t’i përfshini në dietën tuaj të përditshme anti-kandidë. Të gjitha këto ushqime janë antibakteriale, antimikrobike dhe ndihmojnë në rivendosjen e ekuilibrit midis baktereve të mira dhe të këqija.
Hudhra, qepa, shpargu, bananet dhe angjinaret janë të pasura me prebiotikë që ushqejnë bakteret e mira. Konsumoni ushqime të fermentuara si lakër turshi dhe kefir, të cilat janë të pasura me probiotikë, d.m.th. bakteret e mira.
Uthulla e mollës, vaji i rigonit, vaji i kokosit, çaji i luleradhiqes dhe pelinit, si dhe perimet jeshile kanë veti të pastrojnë trupin nga toksinat dhe në të njëjtën kohë të forcojnë dhe forcojnë tretjen dhe imunitetin.
8. Tulsi ose borziloku i shenjtë është një nga bimët mjekësore më të fuqishme dhe zë një vend të veçantë në mjekësinë Ayurvedike. Tulsi ka veti të forta antibakteriale dhe antifungale. Ndihmon në mbrojtjen e baktereve të dobishme në zorrë kur ato ekspozohen ndaj baktereve dhe kërpudhave të dëmshme.
Përveç kësaj, tulsi është një antioksidant i fuqishëm dhe një mjet për pastrimin e trupit nga toksinat. Çaji Tulsi përgatitet në të njëjtën mënyrë si çaji i zi, jeshil ose i bardhë.
Duhet të jeni të durueshëm në trajtimin e kandidës sepse kërkon pak kohë për t'u shëruar plotësisht. Duhen të paktën 3 muaj që sistemi tretës dhe imunitar të kthehen në ekuilibër.
Duke vepruar kështu, është e rëndësishme të ndiqni intuitën tuaj, e cila do t'ju tregojë se cila terapi do t'ju përgjigjet më mirë.
Ne të gjithë jemi unikë në fiziologjinë tonë dhe trupi ynë dhe reagimi i tij ndaj ushqimeve të caktuara na tregojnë se cili është ilaçi i duhur për ne. /Telegrafi/